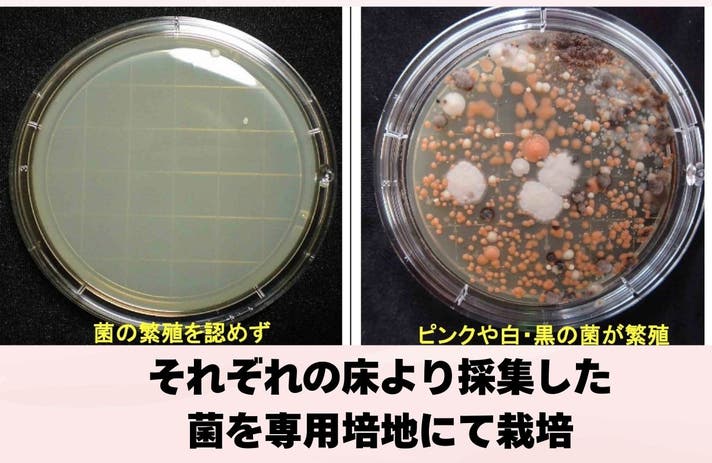

プロジェクト実行者
ストーリー
- 【ワンステップ】浴室のピンク汚れをブロック
- 【時短】2~3週間に1回で綺麗が長続き
- 【非塩素】塩素不使用なので浴室を傷めない

スプレーするだけで
ピンク汚れを長くブロック!
Shell Magic防カビスプレー
こんなお悩み抱えていませんか?


ピンク汚れの原因は…

掃除グッズは塩素系ばかりなので
狭い浴室では臭いが気になります。


Shell Magicは塩素不使用
化学薬品不使用なのでどなたでもお使い頂けます。

使い方はとっても簡単


ホタテの貝殻とバイオで汚れを落とす



ホタテの貝殻とバイオの力で
地球と人にやさしい商品となっております。
エビデンスもしっかり取得

※すべての菌に効くわけではございません。
こんなところにも使えます!


実行者紹介
弊社は愛知県にあります有限会社オブジィーと申します。
2000年に創業し、25年間 人と地球にやさしい商品をコンセプトに商品の開発を行っております。
産業廃棄物を利用することによりごみが減り 地球にやさしい
食品からできた天然素材なので誰にでも使え 人にやさしい
地球と人に優しい会社を本気で目指しております。

リターンについて


リスク&チャレンジ
※本文中に記載させていただいたスケジュールは、あくまでプロジェクト公開時点の予定です。応援購入の性質上、使用部材の供給状況、製造工程上の都合等により配送遅延の可能性もございます。原則として、配送遅延に伴う応援購入のキャンセルはできませんが、リターン配送予定月から3ヵ月を超えた場合には、希望者に限りキャンセルにて対応させていただきます。
サポーターからの応援コメント
文章のトップに戻る
応援購入する
このプロジェクトはAll in型です。目標金額の達成に関わらず、プロジェクト終了日の2025年10月13日までに支払いを完了した時点で購入が成立します。
決済時に安心システム利用料として2.2%(税抜)がかかります。
インボイス(適格請求書):対応可
完成商品 2個セット
3,850円(税込)
・完成した商品 本商品200ml 2個セット
Makuake特別価格2個 3,850円(税込み)
※皆様の応援購入により量産効率が向上した場合、正規販売価格が販売予定価格より下がる可能性もございます
※ご注文状況、使用部材の供給状況、製造工程上の都合等により出荷時期が遅れる場合があります。
完成商品 5個セット
8,250円(税込)
・完成した商品 本商品200ml 5個セット
Makuake特別価格5個 8,250円(税込み)
※皆様の応援購入により量産効率が向上した場合、正規販売価格が販売予定価格より下がる可能性もございます
※ご注文状況、使用部材の供給状況、製造工程上の都合等により出荷時期が遅れる場合があります。
「Makuake(マクアケ)」は、実行者の想いを応援購入によって実現するアタラシイものやサービスのプラットフォームです。このページは、 プロダクトカテゴリの 「スプレーするだけで浴室のピンク汚れをブロック!塩素不使用 浴室用防カビスプレー」プロジェクト詳細ページです。